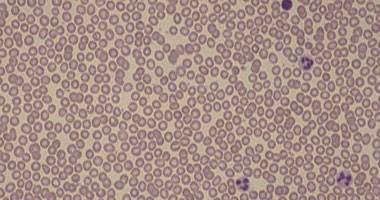

اكتشاف بكتيريا جديدة تعيش على الكافيين
رام الله - شبكة راية الاعلامية :
اكتشاف بكتريا جديدة تدمن القهوة !! فقد اكتشف العلماء نوعا جديدا من البكتريا التى تعيش على مادة الكافيين، والتى انتشرت بشكل كبير فى مياه الصرف الصحى، نظرا لكثرة تناول الإنسان لتلك المادة ولكن ما هى مخاطر تلك الميكروبات وما هو تأثيرها على الإنسان والبيئة المحيطة به؟
ويتساءل الدكتور مجدى بدران فى بداية حديثه عن سؤال هام يبادر لنا جميعا، وقد لا نعلم إجابته وهو لماذا خلق الله الميكروبات فالبعض يتعجب من وجود البكتيريا فى حياتنا ولكن من المؤكد أننا مهما علمنا نجهل أضعاف أضعاف ما نعلم.. ونتعلم كل يوم.
ويشير دكتور مجدى إلى أن هناك العديد من البكتيريا النافعة، ولكن الغريب هو اكتشاف بكتيريا لها دور فى المعالجة البيولوجية لتنقية البيئة من الملوثات! وهى بكتيريا الكافيين أو (سيودوموناس بوتايدا).
ويوضح دكتور مجدى أنه لا خلاف على أن الكافيين أصبح من ملوثات البيئة، حيث تتلوث مياه الكوكب ببقايا العديد من أشكال الكافيين وقد تم اكتشاف أن مياه المحيط الهادى والبحر المتوسط بها مستويات مرتفعة من الكافيين فى عدة مواقع غير متوقعة بعيدة عن السواحل.
وتعد مخاطر تلوث مياه الكوكب بالكافيين قضية جديدة لا تعرف مضاعفاتها ولكن التجارب المعملية بينت أن ارتفاع نسب الكافيين فى المياه يضر بعض الكائنات البحرية (بلح البحر).
وما أظهرته الدراسات الحديثة هو اكتشاف بكتيريا جديدة تعيش فى التربة تدمن الكافيين و تطهر بصورة طبيعية التربة والمياه الجوفية من الكافيين كما تم اكتشاف أربعة أنواع من البروتينات الهاضمة للكافيين.
ويؤكد دكتور مجدى أنه بالإمكان استخدام هذه البكتيريا فى تنقية البيئة من الكافيين، وفعلا نجحت تجارب استخلاص الجين (الشفرة الوراثية) الخاصة بإدمان الكافيين وتكسيره وتم إدخالها بالهندسة الوراثية فى نوع آخر من بكتيريا التجارب سهلة النمو، والتكاثر فى المعمل وأقٌل تكلفة!
ومن الجدير بالذكر أن الكافيين موجود فى القهوة والشاى والكولا والشوكولاتة و تشكل مشتقات الكافيين 65% من المشروبات الغازية المتداولة فى الأسواق العالمية.


